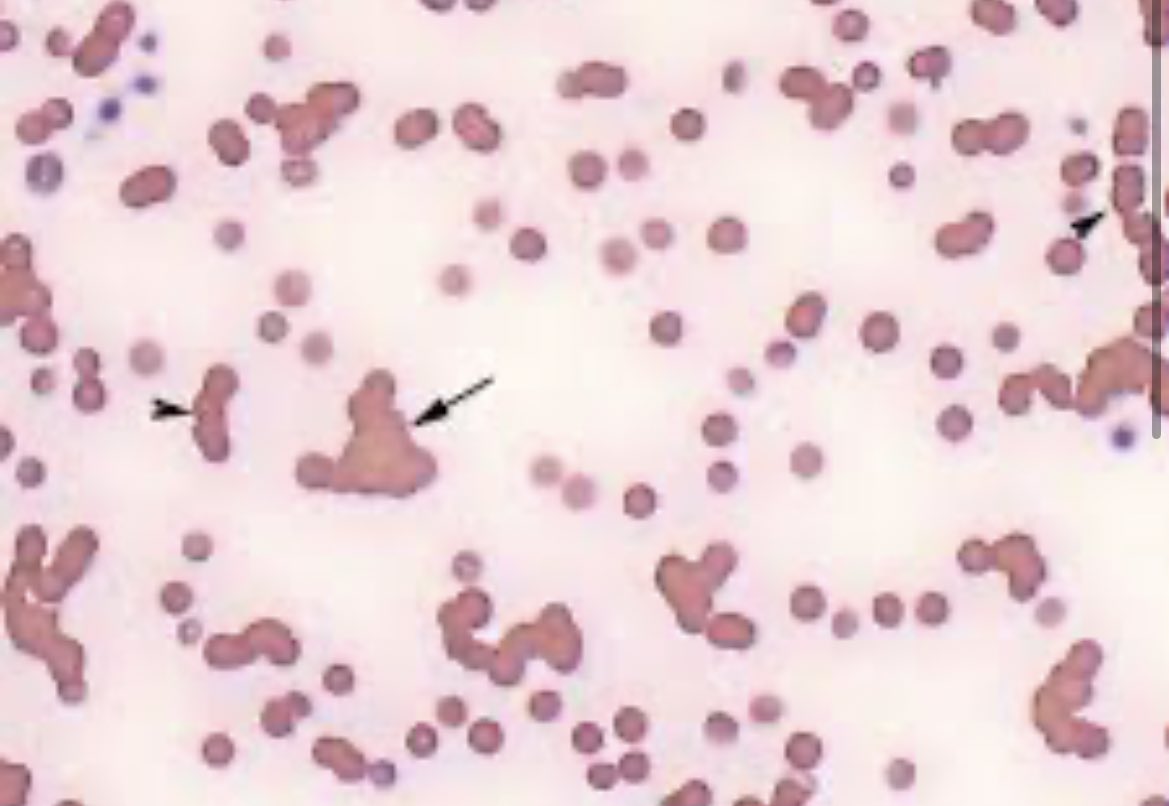
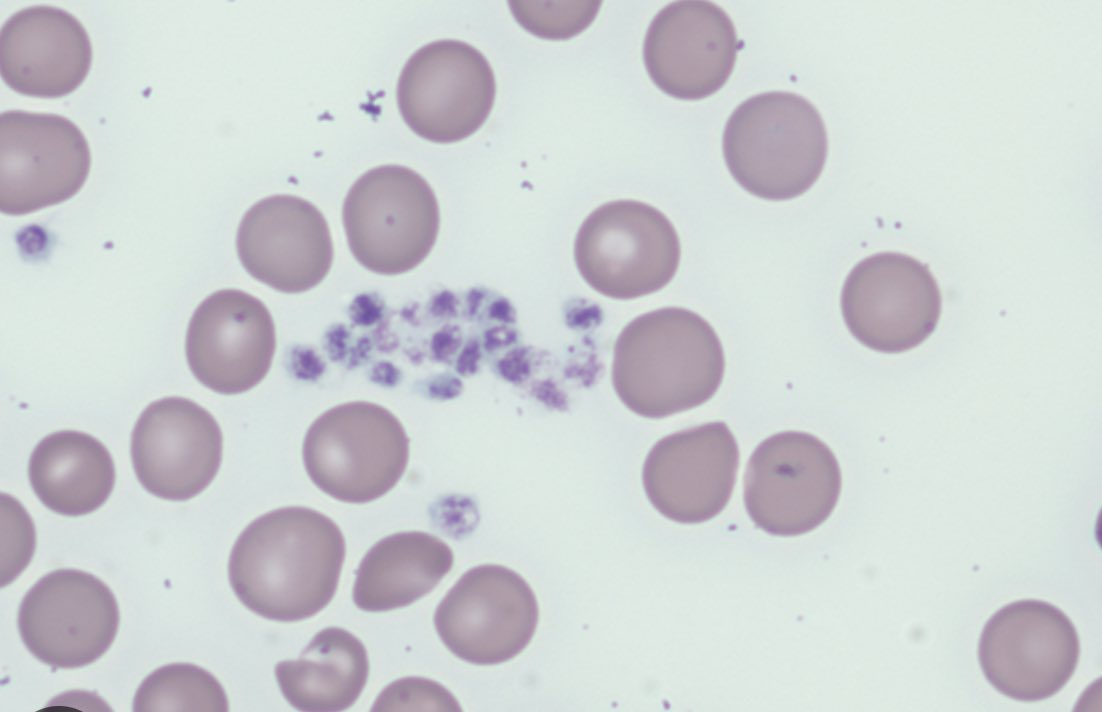
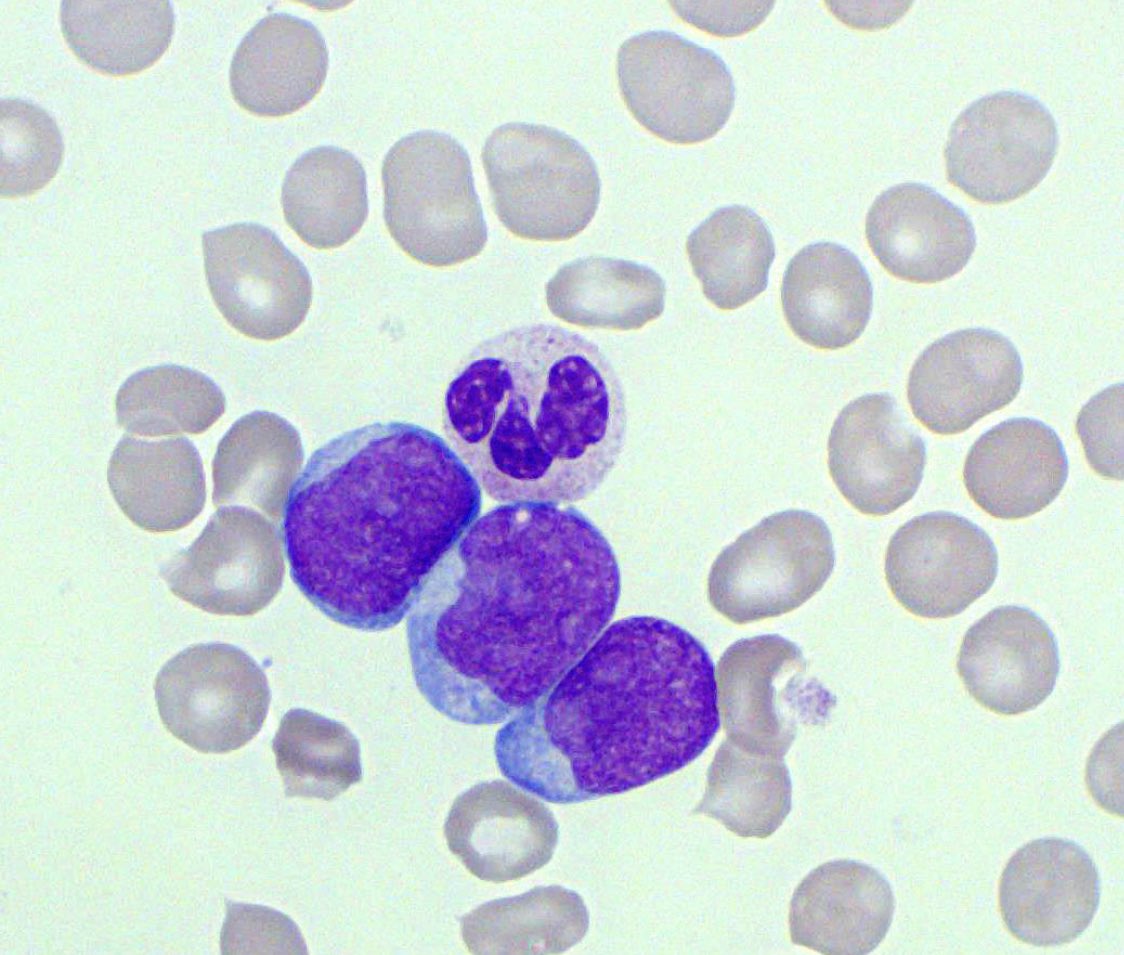

#Hematology
#مختبرات_طبية
موضوع اليوم راح يتكلم عن استخدام بعض خصائص الجهاز الجبار Sysmex XN
والي راح يساعدنا بشكل كبير على تفسير النتائج ، والهدف انه راح يعطيني نتائج اكثر دقة وموثوقية 👌
منشنوا الي شغالين على الجهاز 🙏🏻
#مختبرات_طبية
موضوع اليوم راح يتكلم عن استخدام بعض خصائص الجهاز الجبار Sysmex XN
والي راح يساعدنا بشكل كبير على تفسير النتائج ، والهدف انه راح يعطيني نتائج اكثر دقة وموثوقية 👌
منشنوا الي شغالين على الجهاز 🙏🏻
طبعا المزايا (لتفسير النتائج) كثيرة ومن ضمنها
1-Interpretive program messages (IP Messages)
2- Graphs (Scattergram Patterns)
3- Q- Flag
1-Interpretive program messages (IP Messages)
2- Graphs (Scattergram Patterns)
3- Q- Flag
طبعا وش سالفة البار قراف وايش راح يبين لي ؟
فيه اشياء كثيره راح توضح لي ولازم اتخذ فيها اجراءات تاكيدية ولكن بتكلم عن اكثر ٥ انواع شيوعا
الي هي
RBC Agglutination
Turbidity HGB
PLT Clamp
iRBC
Blast
فيه اشياء كثيره راح توضح لي ولازم اتخذ فيها اجراءات تاكيدية ولكن بتكلم عن اكثر ٥ انواع شيوعا
الي هي
RBC Agglutination
Turbidity HGB
PLT Clamp
iRBC
Blast
وبنهاية الثريد اتمنى انكم استفدتوا وقدرنا نضيف لكم شي جديد
والي حاب معلومات اكثر انا تحت خدمتكم وايضا موظفي سيسمكس ماراح يقصروا معكم👌
والي حاب معلومات اكثر انا تحت خدمتكم وايضا موظفي سيسمكس ماراح يقصروا معكم👌
جاري تحميل الاقتراحات...